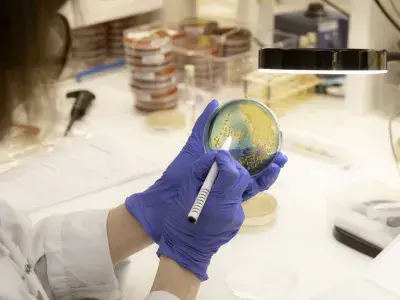

Mis à jour le 08/06/2026
La médecine du futur devient réalité grâce à vos dons
La médecine du futur n’a jamais été aussi proche de nous. Elle s’écrit aujourd’hui dans les 38 hôpitaux de l’AP-HP. Thérapies géniques et cellulaires, intégration de l’intelligence artificielle, assistance robotique de haute précision : les innovations qui semblaient relever de la science-fiction font déjà émerger de nouveaux espoirs de traitement pour les patients. Pour que les dernières avancées quittent les laboratoires et rejoignent nos hôpitaux, votre soutien est indispensable.

La médecine connaît une accélération sans précédent. Thérapies géniques et cellulaires, intégration de l’intelligence artificielle, assistance robotique de haute précision : les innovations qui semblaient relever de la science-fiction font déjà émerger de nouveaux espoirs de traitement pour les patients.
Pour que les dernières avancées quittent les laboratoires et rejoignent le lit du patient, votre soutien est indispensable.
L’AP-HP : Une envergure unique pour des progrès historiques
En tant que premier groupe hospitalo-universitaire et centre de recherche clinique d’Europe (38 hôpitaux, 8 millions de patients par an), l’AP-HP dispose d'atouts uniques :
- Une recherche de pointe : les médecins-chercheurs de l’AP-HP mènent plus de la moitié de la recherche clinique faite en France pour trouver de nouveaux traitements
- Un gisement de données : l’AP-HP possède la plus grande base de données de santé d’Europe, un levier massif pour l’IA et la recherche.
- L'excellence humaine : au-delà de la technique, les équipes de l’AP-HP s’engagent chaque jour à offrir à nos patients une prise en charge humaine et un parcours de soin optimal.
- La transmission : l’AP-HP forme chaque année environ 22 000 étudiants et internes, garantissant l'avenir du système de santé.
Le don : le catalyseur de l'innovation médicale
Une multitude de projets remarquables et innovants sont portés par les équipes de l’AP-HP, en soutenant la Fondation, vous donnez aux équipes soignantes et aux chercheurs les moyens d’agir concrètement. Voici quelques exemples significatifs de ce que pourrait accomplir votre générosité :
Opérer l'inopérable :
Déployer le robot Epione pour traiter des cancers jusqu'ici impossibles à opérer.

Briser les impasses
Développer les médicaments de demain pour les patients sans solution thérapeutique actuelle.
Rayonner à l'international
Financer des formations d’excellence pour que les médecins de l’AP-HP rapportent les meilleures pratiques mondiales.

Transformer votre impôt en projets médicaux
Soutenir la Fondation de l’AP-HP, c’est mettre votre fiscalité au service de l’intérêt général.
En faisant un don, vous bénéficiez d’importants avantages fiscaux :
- Impôt sur la Fortune Immobilière (IFI) : déduisez 75% du montant de votre don de votre IFI (dans la limite de 50 000 € de déduction).
- Impôt sur le Revenu (IR) : déduisez 66% du montant de votre don de votre IR (dans la limite de 20% de votre revenu imposable).
- Impôt sur les Sociétés (IS) : déduisez 60% du montant de votre don de votre IS (dans la limite de 0,5% de votre chiffre d'affaires annuel HT).
Chercheurs et soignants œuvrent sans relâche pour une médecine d’excellence, accessible à tous. Ils comptent sur vous pour transformer ces innovations en réalités concrètes.

